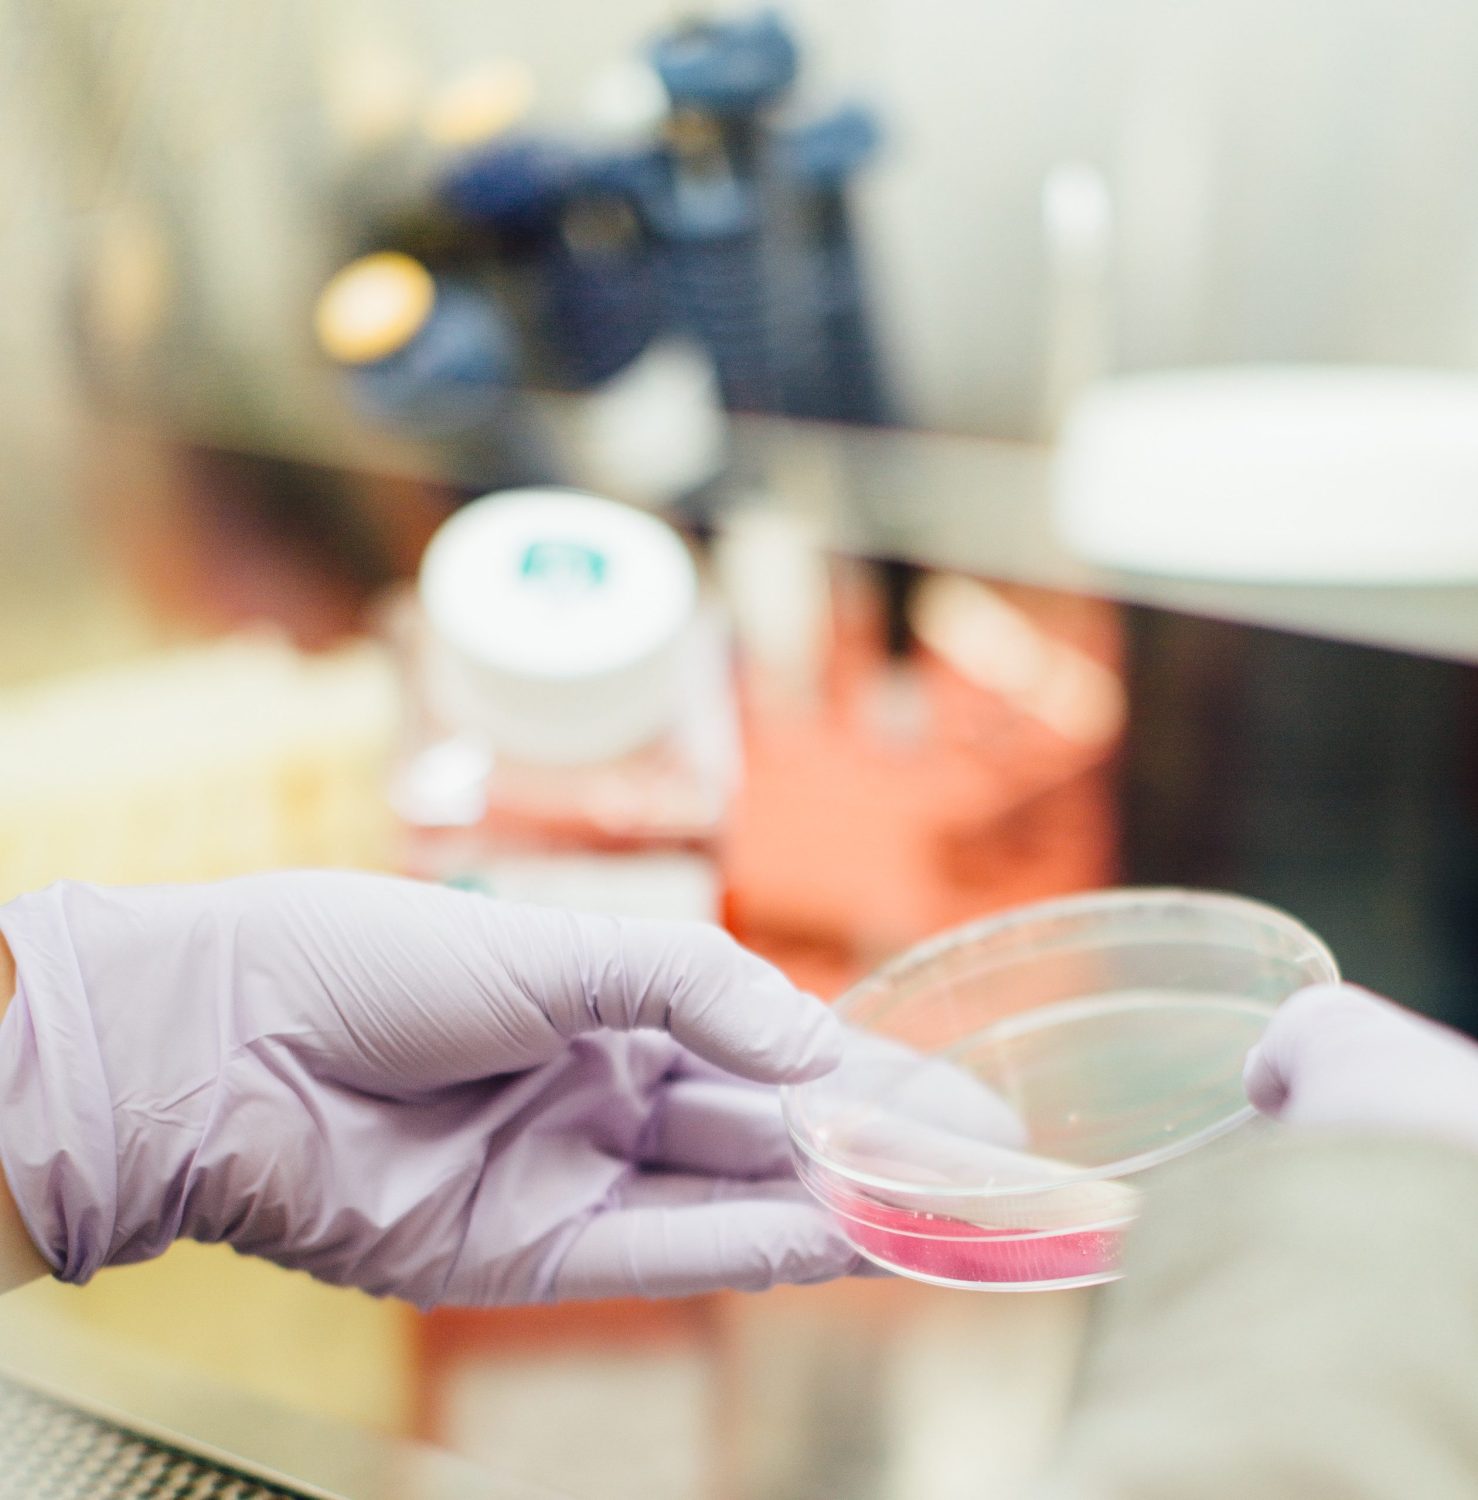
medical specialist

Specialist doctors, also known as consultants or experts, are doctors who focus on a specific area of medicine or a group of patients to diagnose, manage, prevent or treat certain types of symptoms and conditions. A specialist completes additional training and education in a specific area of medicine beyond their general medical degree. They concentrate on a particular branch of medicine and provide expert knowledge and specialized care within their chosen field.
Key Attributes of a Specialist Doctor
- Narrow focus: Specialists concentrate on a specific area of medicine, such as cardiology, orthopaedics, neurology, oncology, etc. Their expertise lies in a particular organ system, disease category, or patient population.
- Advanced expertise: Specialists undergo extensive training, often involving several years of residency and fellowships, to acquire advanced knowledge and skills in their specialized area. This enables them to diagnose, treat, and manage complex medical conditions that require specialized interventions and procedures.
- Referral-based care: Patients are typically referred to specialist doctors by general practitioners when their medical condition requires specialized attention. Specialists work closely with GPs to develop treatment plans, provide specialized interventions, perform surgeries, and offer ongoing care for patients requiring advanced medical interventions.
Common Types of Specialist Doctors
- Paediatricians: They specialize in child care from birth to young adulthood. Some paediatricians also specialize in pre-teens and teens, child abuse, or children’s developmental issues.
- Neurologists: They are specialists in the diagnosis and treatment of nervous system disorders, which includes the brain, spinal cord, and nerves.
- Cardiologists: They are experts in taking care of the heart and blood vessels.
- Dermatologists: They are specialists in treating skin diseases, hair and nail diseases.
- Obstetricians and Gynecologists: These doctors focus on women’s health, including pregnancy and childbirth. OB/GYNs are trained in both areas. But some of them may focus on women’s reproductive health (gynaecologists), and others specialize in caring for pregnant women (obstetricians).
- Allergists/Immunologists: They treat immune system disorders such as asthma, eczema, food allergies, insect sting allergies, and some autoimmune diseases.
- Psychiatrists: These doctors treat people with mental, emotional, or addictive disorders. They can diagnose and treat depression, schizophrenia, substance abuse, anxiety disorders, and sexual and gender identity issues. Some psychiatrists focus on children, adolescents, or the elderly.
- Pathologists: They are doctors that identify the causes of diseases by examining body tissues and fluids under microscopes.
- Haematologists: These are specialists in diseases of the blood, spleen, and lymph glands, like sickle cell disease, anaemia, haemophilia, and leukaemia.
- Oncologists: They are called cancer specialists. They handle chemotherapy treatments and often work with radiation oncologists and surgeons to care for someone with cancer.
- Radiologists: They use X-rays, ultrasound, and other imaging tests to diagnose diseases. They can also specialize in radiation oncology to treat conditions like cancer.
- Nephrologists: They treat kidney diseases as well as high blood pressure and fluid and mineral imbalances linked to kidney disease
- Colon and Rectal Surgeons: These doctors take care of problems involving the small intestine, and colon. They treat colon cancer, haemorrhoids, and inflammatory bowel disease.
- Otolaryngologists: They treat diseases in the ears, nose, throat, sinuses, head, neck, and respiratory system. They also can do reconstructive and plastic surgery on your head and neck.
- Plastic Surgeons: They are also called cosmetic surgeons. They rebuild or repair your skin, face, hands, breasts, or body. That can happen after an injury or disease or for cosmetic reasons.
- Urologists: These are surgeons who care for men and women for problems in the urinary tract, like a leaky bladder. They also treat male infertility and do prostate exams
- Sports Medicine Specialists: These doctors diagnose, treat, and prevent injuries related to sports and exercise.
- Rheumatologists: They specialize in arthritis and other diseases in your joints, muscles, bones, and tendons. You might see them for osteoporosis (weak bones), back pain, gout, tendinitis from sports or repetitive injuries, and fibromyalgia.
- Gastroenterologists: They are specialists in digestive organs, including the stomach, bowels, pancreas, liver, and gallbladder. They also do a colonoscopy and other tests for colon cancer.
- Pulmonologists: These specialists handle problems like lung cancer, pneumonia, asthma, emphysema, and trouble sleeping caused by breathing issues.
While most of the types of medical specialists are interesting, it’s important to understand that some of them are not offered as a course of study in Nigeria. In one of our posts based on choosing a career as a medical doctor, we list a few federal and state schools that offer medicine as a course of study.
Also, both general practitioners and specialist doctors are vital components of the health system, contributing to the well-being of patients, and working in collaboration to deliver comprehensive healthcare services. General practitioners serve as the first point of contact, providing primary care and fostering preventive health practices. Specialist doctors bring their expertise and advanced knowledge to diagnose and treat complex medical conditions. The combined efforts of GPs and specialist doctors enable us to navigate the diverse landscape of healthcare with confidence and improved patient outcomes.
You can decide to venture into any area of specialisation or become a general practitioner in the field of medicine depending on your career goals and level of interest.
Good luck